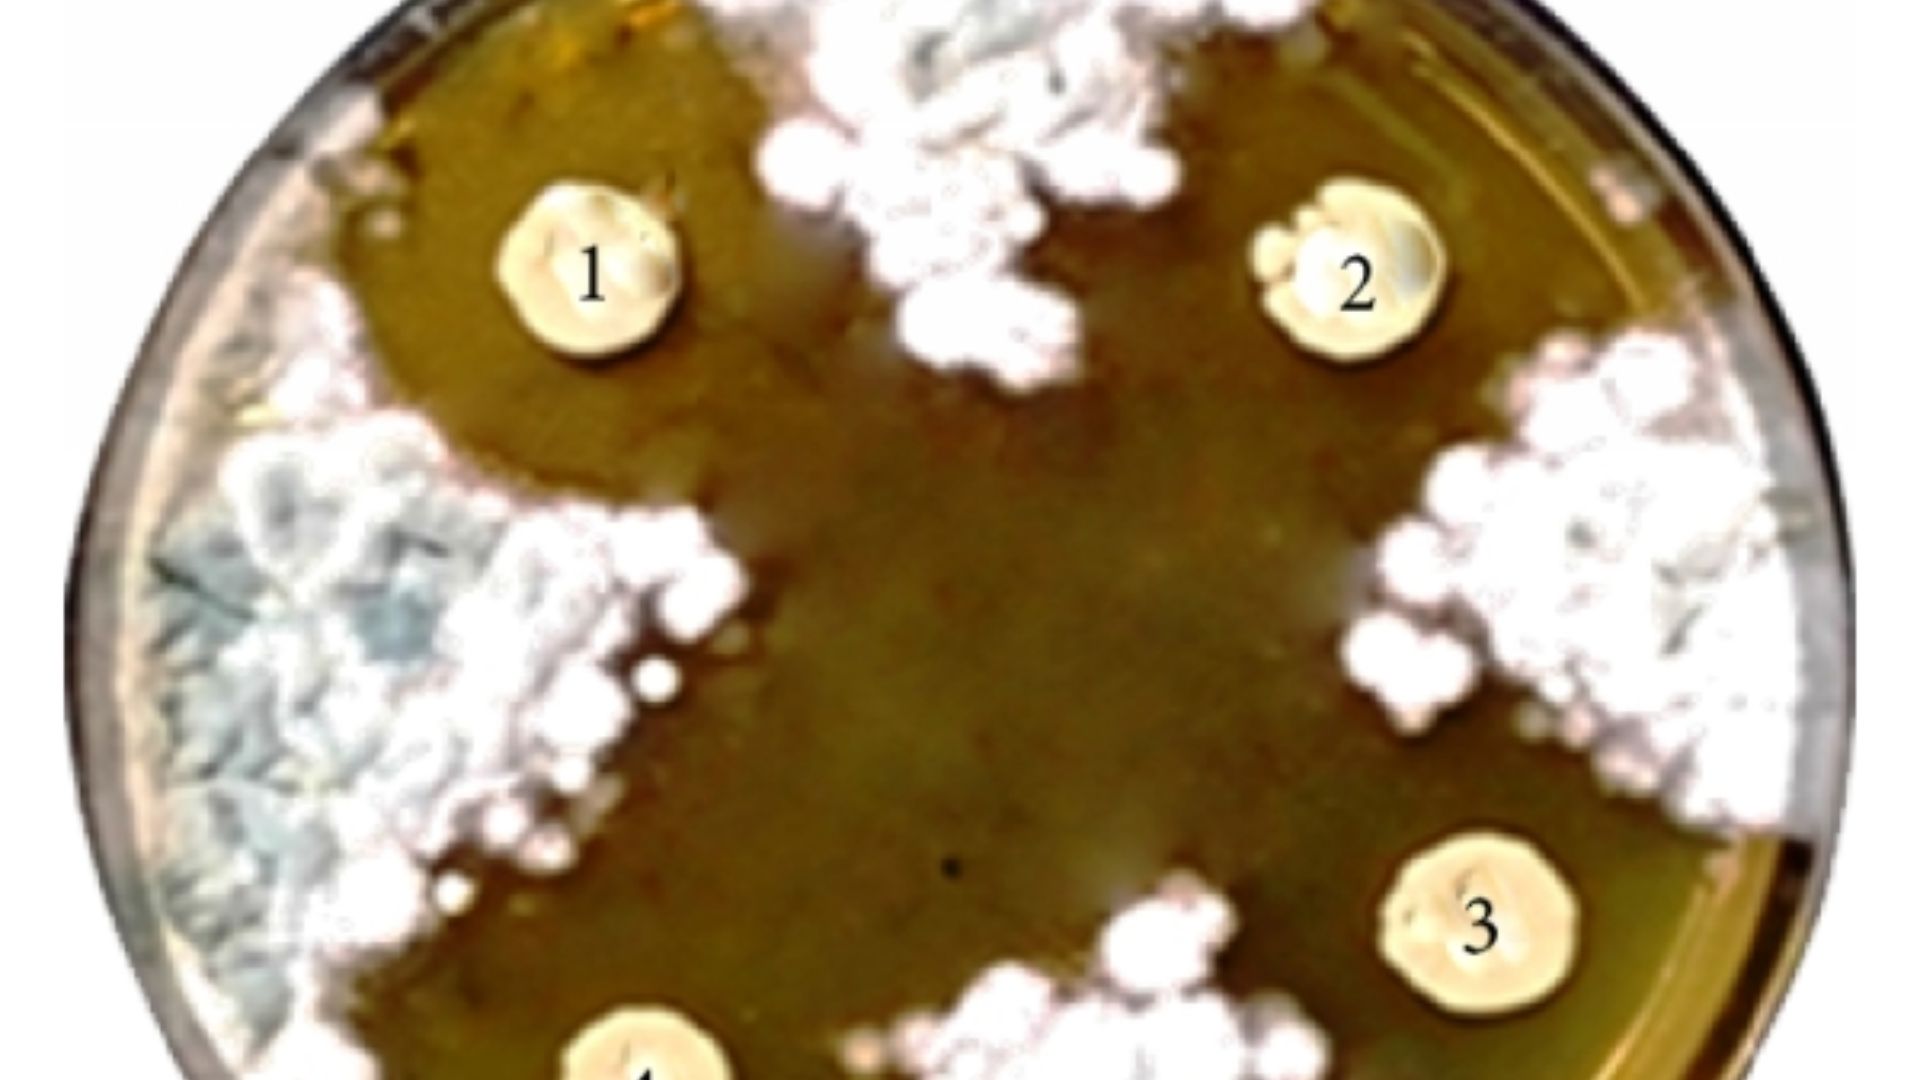
File:Antifungal-activity-of-L.jpg

20 Things You Didn't Know Were Invented By Women
World-Changing Female Inventions
While men like Nikola Tesla and Thomas Edison get more than their due, countless women inventors are overlooked. Females have been behind many of the most influential innovations, from everyday household items to groundbreaking medical discoveries. Here are 20 things you probably didn't know were invented by women.
Midjourney AI, prompted by Netha Hussain on Wikimedia
1. Circular Saw
The circular saw, an essential tool in any warehouse, was invented by Tabitha Babbitt in 1813. She witnessed the men in her community wasting time using a back-and-forth saw, so she attached a circular blade to a spinning wheel for smoother and faster cutting.
2. Dishwasher
You can thank Josephine Cochrane for the fact that you don't have to waste time washing every dish by hand. A wealthy socialite, she invented the washing machine in the late 19th century after being frustrated that her servants kept chipping her fine china.
3. Windshield Wipers
You can thank Mary Anderson for the fact that you can see through your windshield when it's raining. She invented them after noticing how much streetcar drivers struggled, often sticking their heads out the window for visibility, in the rain, sleet, and snow.
4. Life Raft
The modern life raft was invented by Maria Beasley in 1882. Ships already had wooden lifeboats, but they were bulky and unsafe. She was the first to come up with a collapsible, fireproof, and portable life raft that could be quickly deployed in emergencies.
5. Street Sweeper
The street sweeper was created by Florence Parpart in 1896. Her design, which was adopted by municipalities across the US, was horse-drawn, using mechanical brushes and water sprays to clean streets more efficiently, revolutionizing public sanitation.
6. Wireless Transmission Technology
Hollywood actress and inventor Hedy Lamarr developed a system during WWII that involved hopping between different radio frequencies to prevent the enemy from intercepting messages. It later became the foundation for wireless communications that we use every day, like Wi-Fi and Bluetooth.
7. Coffee Filters
Astonishingly, coffee filters weren't invented until 1908, before which, everyone just put up with coffee grounds floating in their cups. Melitta Bentz created the first coffee filter and founded the company Melitta, which still produces a variety of coffee-related products today.
8. Central Heating
Black inventor Alice Parker created central heating in 1919 after noticing how inefficient stoves and fireplaces were at heating rooms. She designed a gas-powered central heating system that could distribute warmth to multiple rooms.
9. Computer Algorithms & Programming
The daughter of Lord Byron, Ada Lovelace, was a brilliant mathematician often credited with being the world's first computer programmer. She developed the first algorithm intended to be read and processed by a machine in the 1840s.
Alfred Edward Chalon on Wikimedia
10. Antifungal Drugs
The world's first effective antifungal drug, Nyastin, used to treat fungal infections, was created by two women, Rachel Fuller Brown and Elizabeth Lee Hazeh. The drug became widely used to treat fungal infections inside the mouth, stomach, and intestines.
11. Beer
Beer may be the quintessential drink of "boys' night," but it started as a women's endeavor in Sumeria and Mesopotamia, where only women were permitted to brew. It was seen as a goddess' gift.
12. CCTV
Closed-Circuit Television (CCTV), which is used for surveillance, security, and traffic control, was invented by Marie Van Brittan Brown in 1966. She created it because she was tired of slow police response times in her neighborhood, so she created a system that would allow homeowners to monitor their properties remotely.
13. Bras
Unsurprisingly, bras were invented by a woman, Caresse Crosby, in 1914. Before then, women wore uncomfortable corsets that were rigid and restricted movement.
14. Kevlar
Kevlar, the exceptionally strong fiber used in bulletproof vests and other protective gear, was developed by chemist Stephanie Kwolek in 1965. While she was experimenting with materials for tires, she discovered a fiber that could be spun into threads and was five times stronger than steel, an invention that has saved countless lives.
15. Chemotherapy
Chemotherapy as a cancer treatment was developed by Dr. Gertrude Elion in the mid-1900s. She created a drug that specifically targets rapidly dividing cells, earning her a Nobel Prize in 1988.
National Cancer Institute on Unsplash
16. Chocolate Chip Cookies
Where would we be without gooey and comforting chocolate chip cookies? They were invented by Ruth Wakefield in 1938 at the Toll House Inn. She added chopped up chocolate to her cookie dough, expecting it to melt and create chocolate cookies, but instead they stayed whole, creating the iconic cookie we know and love.
Food Photographer | Jennifer Pallian on Unsplash
17. Electric Refrigerator
The electric refrigerator was invented by Florence Parpart in 1914. Before her design, which used an electric motor and mechanical system, households relied on iceboxes to keep food fresh.
18. GIFs
Can you imagine where your group chats would be without GIFs? Now a staple of online communication, the compressed, short animation loop known as a GIF was created by Stephanie Craig in 1987.
19. Science Fiction
Science Fiction as a recognized literary genre began with Mary Shelley's groundbreaking novel Frankenstein. In this and her other works, she meshed science with imaginative storytelling and explored themes of life, ethics, and the consequences of technology, forming the foundation of the genre.
20. Stem Cell Isolation
Scientist Ann Tsukamoto managed to isolate human stem cells in 1991, r breakthrough for medical research. This became the foundation of regenerative medicine, blood disease treatments, and bone marrow transplants.
KEEP ON READING
The Love Story Behind the Taj Mahal Was Also a…
Koushik Chowdavarapu on UnsplashThe Taj Mahal is often introduced as…
By Emilie Richardson-Dupuis Apr 2, 2026
JFK's Last Meal Is A Testament To His Character
Walt Cisco, Dallas Morning News on WikimediaHistory often focuses on…
By Sara Springsteen Apr 2, 2026
Public Executions Were Once the Most Attended Events in Town…
Georg Heinrich Sieveking on WikimediaFor centuries, a public execution could…
By Breanna Schnurr Apr 2, 2026
20 Old Hollywood Feuds That Went Beyond The Studio Lot
When The Smiles Stopped. Old Hollywood sold a polished fantasy,…
By Breanna Schnurr Apr 2, 2026
The Coup Triggered by a Pop Song
Matheus Ferrero on UnsplashMost political upheavals have a trigger that…
By Cameron Dick Apr 2, 2026
How The Black Death Spurred the Renaissance
Art Institute of Chicago on UnsplashThe Black Death, which swept…
By Rob Shapiro Apr 2, 2026